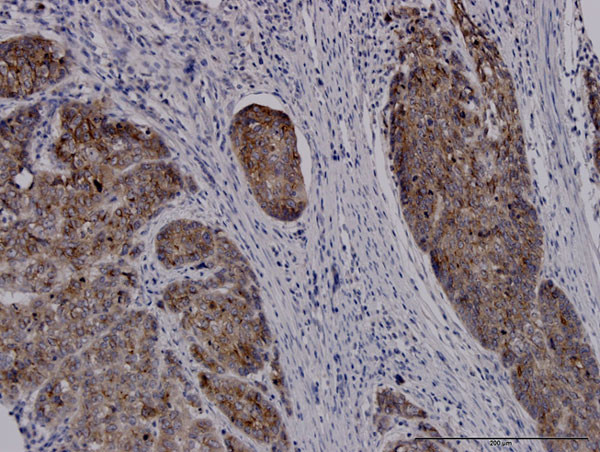
SLC11A2 Antibody in Immunohistochemistry (Paraffin) (IHC (P))

Search
Abnova
SLC11A2 Monoclonal Antibody (4C6)
{{$productOrderCtrl.translations['antibody.pdp.commerceCard.promotion.promotions']}}
{{$productOrderCtrl.translations['antibody.pdp.commerceCard.promotion.viewpromo']}}
{{$productOrderCtrl.translations['antibody.pdp.commerceCard.promotion.promocode']}}: {{promo.promoCode}} {{promo.promoTitle}} {{promo.promoDescription}}. {{$productOrderCtrl.translations['antibody.pdp.commerceCard.promotion.learnmore']}}
产品信息
H00004891-M01J
宿主/亚型
分类
类型
克隆号
抗原
偶联物
形式
浓度
规格
保存条件
运输条件
产品详细信息
Sequence of this protein is as follows: MVLGPEQKMS DDSVSGDHGE SASLGNINPA YSNPSLSQSP GDSEEYFATY FNEKISIPEE EYSCF
Cell culture grade monoclonal antibodies are obtained by purifying "hybridoma culture medium" which completely eliminates any contamination of mice. They have high affinity, high purity, and no contamination.
靶标信息
This gene encodes a member of the solute carrier family 11 protein family. The product of this gene transports divalent metals and is involved in iron absorption. Mutations in this gene are associated with hypochromic microcytic anemia with iron overload. A related solute carrier family 11 protein gene is located on chromosome 2. Multiple transcript variants encoding different isoforms have been found for this gene.
仅用于科研。不用于诊断过程。未经明确授权不得转售。